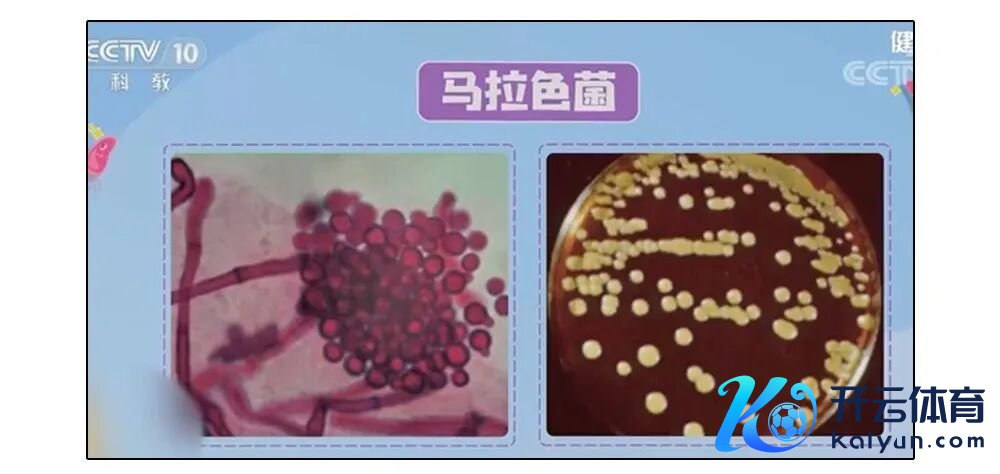

现金九游体育app平台加多患病概率外耳湿疹有三个发展阶段:一朝发现得尽早去病院治否则越拖越严重监制:卢刚 | 责编:刘晶瑶 | 校对:张慧-九游体育官网 九游娱乐「NineGameSports」官方网站

现金九游体育app平台
起原:详细趣味博士实践室
这是一只看似平平无奇的耳朵
但要是你用指甲顺着耳廓刮一刮——


你们不错试试这会儿刮我方耳朵
大略率会刮出一些
油浓重腻黄黄的物资

有的东谈主还能摸到点翘皮
一撕就能撕下一派片皮屑



要是你刮出来的东西仅仅

别垂危,那它确乎仅仅

耳廓这一块儿亦然有皮脂腺的!
何况头颈部皮肤
还是身体皮脂腺密度最大的区域
是以平常就会库库分泌皮脂
而耳朵里还有耵聍腺
平常也会分泌淡黄色、黏稠的耵聍
(俗称耳屎)

于是皮脂和耵聍
就厮混在一齐
组成了你刮出来的那些物资

纵不雅耳廓的地势
可谓坑坑巴巴沟壑纵横

曾有科学家作念过测量
耳廓里褶皱深度能到1cm多

这些沟壑
辞谢了分泌物的散播、掉落
耳廓内部就很容易积蓄出一层了!

要是你刮出来的
是许多碎碎的鳞屑

那就要当心了!可能是

此时你的耳廓皮肤
油脂分泌终点
给“马拉色菌”创造了迢遥养殖的条目
而“马拉色菌”又会
破裂皮肤樊篱
促进油脂进一步终点分泌
耳廓就会
发红、起皮、浓重、瘙痒
随意一刮就能刮下一堆鳞屑!

要是你天天熬夜、爱浓重重口饮食
就要当心沾上这谬误


过度增长的皮脂
会给脂溢性皮炎提供契机!
另外,还需要当心
是不是开空调开的!

空调间空气不畅、相比干燥
再加上空调不干净吹出尘螨
王人可能影响你的皮肤,加多感染契机
严重瘙痒、难受致使流脓的话
那还是需要去病院看一下的

要是你刮一圈耳廓
刮到了麻麻赖赖的小疙瘩

那就要当心,可能是

要是你是这情况
不出巧合是过敏了
外耳湿疹是
常发生在外耳谈、耳廓周围的
变态响应性疾病
王人是常见的外耳湿疹过敏原
另外
像民众一戴耳机就几小时致使
通宵常常常使劲挖耳朵
也容易让耳朵变脆弱,加多患病概率
外耳湿疹有三个发展阶段:

一朝发现得尽早去病院治
否则越拖越严重
监制:卢刚 | 责编:刘晶瑶 | 校对:张慧


